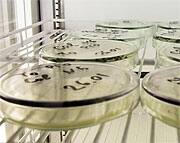
Linus Pauling: The Scientist

Life Extension Magazine®
At the time of this writing, three nuclear reactors in Japan were crippled, releasing radioactive particles into the air, sea, and groundwater. A potential medical crisis has been generated—one that Life Extension® members were warned about long ago.1,2 Just days after the devastating tsunami struck Japan’s nuclear reactors—suppliers of the radioprotective compound potassium iodide had no inventory left.3 The reason potassium iodide needs to be available for a nuclear emergency is that the most carcinogenic of the radioactive isotopes of iodine (iodine-131) can destroy thyroid tissue and cause cancer. If potassium iodide is taken in time, it saturates the thyroid gland with iodine so the radioactive iodine cannot easily enter. Potassium iodide is the most important primary intervention to protect against thyroid cancer. It has long been approved by the FDA for this purpose.4 Based on our warnings dating back to 2002, most of our members had already stocked up and were prepared in case of emergency. Not everyone heeded our prior advice. Had there been a nuclear emergency in the United States, those without immediate access to potassium iodide could have been exposed to lethal amounts of radioactive iodine. Radioactive particles damage far more than the thyroid gland, as leukemia and other cancers are elevated in those exposed to radiation. We know that radiation inflicts free radical damage to our cells. Fortunately, supportive data reveals many of the nutrients already taken by Life Extension members may optimize one’s defenses against radiation exposure. What Are the Real Risks Americans Face from Japan?In the May 2002 issue of Life Extension Magazine®, we published an article titled “Vindication for Linus Pauling.”5 This article (re-published with this month’s issue), described a belated report from our Federal government whereby they admitted that above-ground nuclear testing that took place between 1951 and 1962 directly caused at least 15,000 cancer deaths in the United States.6,7
If it were not for Linus Pauling, above-ground nuclear testing would have continued, killing thousands more Americans from what the Federal government initially claimed was “harmless” radioactive ash.5,7,8 At the time that Linus Pauling was warning about the lethal dangers of radioactive fallout, our Federal government was devising ways to have him (and others) incarcerated on pretenses that they were enemies of the state. But it was not only above-ground testing in the United States that was causing these cancers. Above-ground nuclear testing in the former Soviet Union and on Pacific Islands used by the US and its allies was also generating radioactive particles that reached the United States.7,9,10 We know today that small amounts of radiation from the crippled Japanese reactors are being detected in the United States.11,12 Government officials state there is no danger. The track record of our government when it comes to recognizing the long-term consequences of radiation exposure, however, is quite dismal. Since most Life Extension members recognize the dangers that free radicals pose to healthy tissues, they are already obtaining some degree of protection by taking nutrients that boost natural protection against radiation. In the event that radiation levels in the United States spike, it would appear prudent to increase one’s ingestion of the specific nutrients that are described in this article. A Bacterium That Thrives Inside Nuclear Reactors!Most people think radiation is toxic to all living organisms. Not so with a bacterium called D. radiodurans,13 whose ultra-high levels of antioxidants superoxide dismutase (SOD) and catalase enable it to thrive inside nuclear reactors.14 Radiation acutely kills by inflicting free radical damage to life-sustaining cells. Due to its naturally high antioxidant status, D. radiodurans can withstand a radiation dose that is 3,000 times greater than what would kill a human.15,16 Delicate cellular structures are oxidized in the presence of high levels of radiation.17 Intriguing data suggests that maintaining high levels of antioxidants confers at least partial protection against radiation-induced free radicals.18 So while it is important to have potassium iodide on hand to protect the thyroid gland in case of a nuclear emergency,19 maintaining high cellular antioxidant levels could add an additional layer of protection to cells throughout the body.20,21 This article first explains how potassium iodide protects the thyroid gland and then more importantly, describes the specific antioxidants and other nutrients that have demonstrated radiation-protective effects in peer-reviewed published studies. Potassium Iodide: First Line DefenseThyroid cancer is the most common malignancy caused by exposure to materials released from damaged nuclear power plants.22 Reactor accidents release a number of radioactive elements, the most common of which is called iodine-131.22,23 Radioactive iodine is readily absorbed into the body primarily by inhalation of contaminated air and also by ingestion of contaminated vegetation, dairy, and meat. It is rapidly taken up into the thyroid gland.24 In the thyroid, ionizing radiation given off by the isotope damages DNA and causes cancer. You can block absorption of radioactive iodine into the thyroid gland by taking a 130 mg dose of potassium iodide not later than 2 hours after possible inhalation or ingestion of radioactive iodine. (Note that 130 mg is the adult dosage. The dose for children ages 3-18 years old is 65 mg; the dose for children 1 month-3 years is 32 mg, and the dose for infants up to 1 month old is 16 mg.)23-26 The thyroid gland absorbs all forms of iodine equally; supplying the body with optimal amounts of iodine in the form of potassium iodide prevents radioactive iodine from reaching vulnerable thyroid tissue in appreciable amounts. A dose of potassium iodide taken appropriately can reduce the risk of thyroid cancer by a factor of 3 and is the single most effective means of preventing thyroid cancer following a nuclear disaster.23,24 Keep potassium iodide tablets readily available in your home, office, and any vehicle—there is not yet sufficient supply nor production capacity to obtain them during an actual event. (Despite the Congressional legislation mandating it be available, only the state of Vermont has implemented a program for distributing potassium iodide to its citizens living within 10 miles of the state’s nuclear facilities.)27 Potassium iodide, however, should not be taken on a regular basis as general protection. There are other nutrients, however, that have been shown to confer a multitargeted radioprotective benefit. They may help to maximize your body’s ability to withstand the effects of ionizing radiation, the source of free radical damage that ultimately leads to radiation-induced cancer.28-34 PolyphenolsPolyphenols are versatile molecules found in plants. They act across a range of biomolecular pathways in the body, including favorable modification of gene expression that protects tissues from ionizing radiation.35,36 Resveratrol, quercetin, and green tea polyphenols rank among the best-studied and most potent radioprotectants in this class. Resveratrol is both a radioprotector in healthy tissue and also has antitumor activity.37,38 In animal models, resveratrol has been shown to protect chromosomes from radiation-induced damage.39 Its antioxidant properties prevent radiation toxicity to animal liver and small intestines, two tissues most immediately sensitive to radiation’s ill effects.40 Quercetin and its related compounds protect lipids and proteins from otherwise-lethal doses of gamma radiation, again largely through their antioxidant properties.41 Quercetin and other polyphenols not only provide chromosomal radioprotection, but also shield mitochondrial DNA from radiation-induced oxidant damage.42 Quercetin also ameliorates biochemical changes in human white blood cells following radiation exposure.43 The polyphenol epigallocatechin gallate (EGCG), derived from green tea, also protects animals from whole-body radiation, blocking lipid oxidation and prolonging life span.44 Green tea extracts can protect rapidly reproducing cells in the intestine and hair follicles from the damaging effects of radiation therapy, a form of radiation exposure far more intense than typical computed tomography (CT) doses—and one that more closely resembles the immediate effects of exposure to a nuclear plant disaster.45,46
SoySoybeans contain a wealth of health-promoting substances, among them several with remarkable radioprotective effects. Genistein, an isoflavone, can protect mice from ionizing radiation injury after a single dose.51 One mechanism is its protection against radiation-induced lipid peroxidation, which when unchecked disrupts cell membranes and structures.52 Genistein also stimulates production of red and white blood cells following whole-body radiation, again after as little as a single dose.53,54 (Blood stem cells in bone marrow are among the most vulnerable to radiation’s deadly effects.) Because of its powerful induction of cytokines that stimulate new blood cell formation, genistein is under intensive study as a way to protect military and civilian personnel against a potential nuclear threat.55 Soybeans also contain a radioprotective enzyme inhibitor known as the Bowman-Birk inhibitor (BBI).56 BBI activates genes involved in DNA repair, making it among the most valuable compounds for preventing or mitigating the effects of radiation toxicity.57,58 BBI also stabilizes enzymes that would otherwise produce radiation-induced arrest of skin cell growth.59 Remarkably, BBI enhances survival of healthy cells, but not diseased cells, following radiation exposure.60,61 BBI survives processing in commercial soybean products (e.g., soy milk, soybean concentrate, and soy protein isolates), making it a highly accessible radioprotectant.62,63 Curcumin and Other Plant ExtractsCompelling scientific evidence suggests that many plant extracts have valuable gene expression-modifying effects that are relevant in protecting our bodies from radiation exposure.
Curcumin, derived from the curry spice turmeric, exerts powerful radioprotective effects as a result of its antioxidant and detoxifying characteristics.64 Curcumin supplements reduce DNA damage and tumor formation in rats; they reduce both DNA damage and lipid peroxidation in cultured human white blood cells.65,66 Curcumin has “dual action.” Its antioxidant effects protect normal tissue from radiation. But it also upregulates genes responsible for cell death in cancers, enhancing tumor destruction by radiation.67 The result is increased survival in animals exposed to high-dose radiation.68 Together, garlic and ginger also afford significant radioprotection. Garlic’s high sulfur content supports natural antioxidant systems.69 Garlic extracts protect red blood cells from radiation damage by a glutathione-related mechanism.70 In mice, garlic extracts have been shown to prevent radiation damage to chromosomes in vulnerable bone marrow cells.71 Via a discrete physiological mechanism, garlic extracts downregulate X-ray-mediated increases in the inflammatory nuclear factor-kappaB (NF-kB) system.72 Ginger extracts boost glutathione activity and reduce lipid peroxidation by a separate and complementary mechanism.73 These extracts directly scavenge a host of free oxygen and nitrogen radicals immediately following their formation by radiation.74-76 Lab studies show that extracts of ginkgo biloba reduce the effects of clastogenic factors—external materials (including plutonium and other radioactive substances) that fragment or delete DNA and inflict chromosomal damage, leading to mutation and cancer proliferation.77,78 This effect is so powerful that it proved useful in treating workers at the Chernobyl nuclear plant long after their exposure.79 More recently, ginkgo extracts proved to protect animals’ organs from direct radiation-induced damage.80 Ginkgo also protected humans from cell damage following radioactive iodine treatment for hyperthyroid Grave’s disease.81 Ginseng is another plant important in traditional medicine that confers substantive radioprotective effects.82,83 A variety of ginseng extracts have been shown to protect against radiation-induced DNA damage.84-86 It protects hair follicles and other rapidly reproducing (but healthy) tissues from damage by radiation.87,88 Its antioxidant effects have resulted in protection of a variety of radiation-sensitive tissues, including cells in bone marrow, spleen, and testicles.82,89 Ginseng’s immunomodulatory effects make it especially useful in defending our bodies against the ravages of radiation injury.90 A North American ginseng extract was recently found to protect human white blood cells from DNA damage even up to 90 minutes following radiation exposure.91 That makes it of great interest to defense and national security researchers—and to the general public in an era of concern about nuclear plant safety.91 Silymarin, an active compound found in milk thistle, is well known for its ability to protect liver cells from alcohol and various chemical toxins. Less well known is its power to protect liver tissue from radiation damage as well.92,93 It reduces DNA damage and extends survival in animals exposed to dangerous levels of radiation.94 Silymarin’s free radical-scavenging and direct antioxidant effects are credited with producing these results.95
N-Acetyl CysteineN-acetyl cysteine or NAC is a sulfur-containing compound that supports natural intracellular antioxidant systems, particularly glutathione, rendering it an effective radioprotective agent.96 NAC minimizes liver damage from radiation in mouse models, reducing oxidative damage and resultant DNA damage—both before and after radiation exposure.97,98 By a separate underlying mechanism of action, NAC stimulates release of cytokines known to protect bone marrow against radiation injury.99 NAC also protects bone marrow cells from radiation, largely by preventing DNA damage.100,101 A multi-compound mixture including vitamins C and E plus NAC significantly increased 30-day survival of mice exposed to a potentially lethal dose of X-rays.102 Remarkably, the effect was the same whether the supplement was given before or after the exposure.
S-adenosylmethionine (SAMe)Like NAC, S-adenosylmethionine (SAMe) is a powerful compound essential for maintaining cellular levels of glutathione.103,104 Enzymes vital for DNA repair (and hence cancer protection) can’t function properly in the absence of methyl donors such as SAMe.105 In early 2010 we learned that ionizing radiation suppresses SAMe levels in animal models.106 Increasing the animals’ SAMe levels, on the other hand, minimized DNA damage from ionizing radiation.106 Antioxidant VitaminsThe “ACE” vitamins (A, C, and E) offer proven antioxidant protection as a result of their molecular structures. High intakes of these vitamins and other antioxidants have been shown to protect airline pilots from radiation-induced chromosomal damage,107 an occupational hazard for those who work at high altitudes. ACE supplements have been proposed as “space foods” to protect astronauts from high radiation levels.108 Beta-carotene, the precursor of vitamin A, was first used clinically in the wake of the Chernobyl nuclear accident as a first-line treatment for children from the region. Supplementation reduced the amount of radiation-induced oxidized lipids.109 More controlled animal studies showed that vitamin A could reverse radiation-induced gene expression abnormalities that could lead to cancer.110-112 Other studies show that vitamin A ameliorates other radiation effects and enhances death of cancerous cells.113 Still other studies reveal that vitamin A can actually prevent radiation-induced death of healthy cells.114 Vitamin C, together with natural antioxidant systems such as glutathione, helps protect DNA and chromosomes from oxidative damage.115-117 Vitamin C also inhibits radiation-induced death of human blood cells through modulation of protective gene expression.118 Remarkably, vitamin C can counteract radiation-induced “long-lived radicals” (LLRs) that destabilize chromosomes and induce cancerous mutations.119 The ability to counter both classical radicals and LLRs may be vital in preventing genetic damage from radiation.119 Like vitamin C, vitamin E quenches free radicals once they form, reducing their toxicity, an effect vital in radioprotection.28 Importantly, vitamin E enhances the growth-inhibiting effect of radiation on cancer tissue while simultaneously protecting normal cells.120 Animal studies show that vitamin E significantly protects mice from dying after exposure to otherwise lethal levels of gamma rays.121 Intriguingly, this effect is the result of modulation of cytokines; it is accompanied by valuable increases in new blood cell formation suppressed by radiation.121,122 A remarkable study among X-ray technicians reveals just how powerful antioxidant vitamins can be. Radiology technicians are nominally protected by elaborate shielding, but they’re still exposed to unnaturally high levels of radiation over the course of a lifetime. As a result, they tend to have higher levels of tissue oxidation. But when a group of techs was supplemented with vitamins C (500 mg) and E (150 mg) daily for 15 weeks, their markers of tissue oxidation plummeted, and their levels of natural antioxidants (such as glutathione and glutathione peroxidase in red blood cells) rose significantly.123
Lipoic AcidLipoic acid is often referred to as the “universal antioxidant” because it quenches free radicals in both aqueous and lipid-soluble environments, such as cellular membranes.124 Lipoic acid exists in two mirror-image forms: R-lipoic acid and S-lipoic acid. While most commercially available products contain a 50:50 mixture of the two forms, only R-lipoic acid is produced by life processes and is thus likely to be the more potent of the two.125,126 Compelling evidence suggests that lipoic acid may offer important protection against the threats posed by various types of radiation exposures. When used in combination with other antioxidants including selenium, vitamin C, vitamin E, N-acetyl cysteine, and coenzyme Q10, lipoic acid helped improve survival of mice following total-body irradiation. This study was particularly noteworthy because the antioxidant combination was effective even when administered 24 hours after a dose of radiation exposure that is often lethal.127 Lipoic acid shows benefits for supporting the immune health of individuals who were involved in the clean-up of the Chernobyl nuclear accident, even years after the event. Eleven to twelve years after the Chernobyl clean-up, study participants received 600 mg of lipoic acid daily for two months. Signs of general immune health improved, and white blood cells called neutrophils demonstrated an improved ability to ingest invading cells and cellular debris.128 Radiation therapy as a component of cancer treatment frequently causes adverse effects on skin health such as swelling and a sunburned appearance. When animal skin cells were incubated with lipoic acid, they experienced less cell injury, compared with skin cells that received radiation but no lipoic acid. These promising findings suggest that lipoic acid may have important applications in preserving skin health in individuals who must undergo cancer radiation therapy.129
Trace MineralsYour body’s internal antioxidant defenses, including superoxide dismutase, catalase, and glutathione peroxidase all depend on trace minerals as cofactors for their function. Zinc and manganese are of particular importance for sustaining whole-body resistance to ionizing radiation. Zinc supplements have been shown to protect rats from oxidative damage to their red blood cells induced by radioactive iodine.130,131 And a zinc supplement protected bone marrow, but not tumor cells, from radiation-induced damage.132 Since mitochondria produce huge amounts of free radicals, they are especially susceptible to radiation damage. Both zinc and manganese provide powerful mitochondria-specific radioprotection in animal studies.133 Other Potent Radioprotective NutrientsMost nutrients with powerful antioxidant activity can be expected to protect you against radiation exposure from medical tests and from temporary increases in radiation in the environment.134 In addition to those already examined, there’s good evidence for radioprotection by spirulina extracts, which protect bone marrow cells from DNA damage.135 Melatonin also protects dividing cells and circulating blood cells from chromosomal injury by radiation.136,137 Licorice extracts block DNA damage and protect cellular organelles from radiation.138 The Indian gooseberry (Emblica officianalis) increases survival time and reduces mortality of mice exposed to whole-body radiation.139 Effects include protection against lipid peroxidation and protection of rapidly-dividing cells in the intestine.140 Carnosic acid and other rosemary extracts protect against DNA damage through their antioxidant activity, both before and after radiation exposure.141
SummaryPotassium iodide is the single most important intervention to prevent lethal damage from radiation exposure. Life Extension® long ago warned the American public to keep supplies of potassium iodide on hand in the event of a nuclear catastrophe. Not everyone heeded our warning. As we predicted, the world’s leading potassium iodide makers failed to maintain adequate supplies and ran out amidst Japan’s ongoing nuclear disaster. In addition to keeping adequate supplies of potassium iodide on hand for short-term radioprotection, there exists a broad array of scientifically-validated nutrients that may optimize your body’s natural defenses against radiation exposure. If you have any questions on the scientific content of this article, please call a Life Extension® Health Advisor at |
| References |
| 1. Block M. Potassium iodide. Insurance against a radiation emergency. Life Extension Magazine®. 2002 Dec;8(12):42-8. 2. VanZile J. Protecting yourself in a nuclear emergency. Life Extension Magazine®.2004 Dec;10(12):56-62. 3. Pollack A. Anxiety over radiation drives a sales surge for a drug against thyroid cancer. The New York Times. March 15, 2011. 4. Weiss JF, Landauer MR. History and development of radiation-protective agents. Int J Radiat Biol. 2009 Jul;85(7):539-73. 5. Faloon W. As We See It: Vindication for Linus Pauling. Life Extension Magazine®. 2002 May;8(5). 6. Available at: http://archives.cnn.com/2002/US/03/01/nuclear.fallout/index.html. Accessed April 1, 2011. 7. Gilbert ES, Land CE, Simon SL. Health effects from fallout. Health Phys. 2002 May;82(5):726-35. 8. Kerber RA, Till JE, Simon SL, et al. A cohort study of thyroid disease in relation to fallout from nuclear weapons testing. JAMA. 1993 Nov 3;270(17):2076-82. 9. Available at: http://www.rense.com/general20/atom.htm. Accessed April 1, 2011. 10. Gilbert ES, Huang L, Bouville A, Berg CD, Ron E. Thyroid cancer rates and 131I doses from Nevada atmospheric nuclear bomb tests: an update. Radiat Res. 2010 May;173(5):659-64. 11. Power S. Radiation traces found in U.S. milk. Wall Street Journal. March 31, 2011. 12. Available at: http://www.livescience.com/13507-infographic-japan-radiation-levels.html. Accessed April 4, 2011. 13. Slade D, Radman M. Oxidative Stress Resistance in Deinococcus radiodurans. Microbiol Mol Biol Rev. 2011 Mar;75(1):133-91. 14. Available at:http://www.thelivingcosmos.com/Extremophiles/RadiationResistant_12May06.html. Accessed March 29, 2011. 15. Patel BA, Moreau M, Widom J, et al. Endogenous nitric oxide regulates the recovery of the radiation-resistant bacterium Deinococcus radiodurans from exposure to UV light. Proc Natl Acad Sci U S A. 2009 Oct 27;106(43):18183-8. 16. Available at: http://web.mst.edu/~microbio/BIO221_2007/D_radiodurans.htm. Accessed March 29, 2011. 17. Cadet J, Douki T, Ravanat JL. Measurement of oxidatively generated base damage in cellular DNA. Mutat Res. 2011 Feb 15. 18. Malhomme de la Roche H, Seagrove S, Mehta A, Divekar P, Campbell S, Curnow A. Using natural dietary sources of antioxidants to protect against ultraviolet and visible radiation-induced DNA damage: an investigation of human green tea ingestion. J Photochem Photobiol B. 2010 Nov 3;101(2):169-73. 19. Jang M, Kim HK, Choi CW, Kang CS. Thyroid dose estimation with potassium iodide (KI) administration in a nuclear emergency. Radiat Prot Dosimetry. 2008;132(3):303-7. 20. Thompson JS, Chu Y, Glass J, Tapp AA, Brown SA. The manganese superoxide dismutase mimetic, M40403, protects adult mice from lethal total body irradiation. Free Radic Res. 2010 May;44(5):529-40. 21. Wambi CO, Sanzari JK, Sayers CM, et al. Protective effects of dietary antioxidants on proton total-body irradiation-mediated hematopoietic cell and animal survival. Radiat Res. 2009 Aug;172(2):175-86. 22. Williams D. Radiation carcinogenesis: lessons from Chernobyl. Oncogene. 2008 Dec;27 Suppl 2:S9-18. 23. Jang M, Kim HK, Choi CW, Kang CS. Age-dependent potassium iodide effect on the thyroid irradiation by 131I and 133I in the nuclear emergency. Radiat Prot Dosimetry. 2008;130(4):499-502. 24. Jaworska A. Iodine prophylaxis following nuclear accidents. Tidsskr Nor Laegeforen. 2007 Jan 4;127(1):28-30. 25. Takamura N, Nakamura Y, Ishigaki K, et al. Thyroid blockade during a radiation emergency in iodine-rich areas: effect of a stable-iodine dosage. J Radiat Res (Tokyo). 2004 Jun;45(2):201-4. 26. Available at:http://www.fda.gov/Drugs/EmergencyPreparedness/BioterrorismandDrugPreparedness 27. Carney JK, deFlorio F, Erickson N, McCandless R. Enhancing nuclear emergency preparedness: Vermont’s distribution program for potassium iodide. J Public Health Manag Pract. 2003 Sep-Oct;9(5):361-7. 28. Riley PA. Free radicals in biology: oxidative stress and the effects of ionizing radiation. Int J Radiat Biol. 1994 Jan;65(1):27-33. 29. Fang YZ, Yang S, Wu G. Free radicals, antioxidants, and nutrition. Nutrition. 2002 Oct;18(10):872-9. 30. Weiss JF, Landauer MR. Radioprotection by antioxidants. Ann N Y Acad Sci. 2000;899:44-60. 31. Weiss JF, Landauer MR. Protection against ionizing radiation by antioxidant nutrients and phytochemicals. Toxicology. 2003 Jul 15;189(1-2):1-20. 32. Klingler W, Kreja L, Nothdurft W, Selig C. Influence of different radioprotective compounds on radiotolerance and cell cycle distribution of human progenitor cells of granulocytopoiesis in vitro. Br J Haematol. 2002 Oct;119(1):244-54. 33. Okunieff P, Swarts S, Keng P, et al. Antioxidants reduce consequences of radiation exposure. Adv Exp Med Biol. 2008;614:165-78. 34. Vijayalaxmi, Reiter RJ, Herman TS, Meltz ML. Melatonin reduces gamma radiation-induced primary DNA damage in human blood lymphocytes. Mutat Res. 1998 Feb 2;397(2):203-8. 35. Annabi B, Lee YT, Martel C, Pilorget A, Bahary JP, Beliveau R. Radiation induced-tubulogenesis in endothelial cells is antagonized by the antiangiogenic properties of green tea polyphenol (-) epigallocatechin-3-gallate. Cancer Biol Ther. 2003 Nov-Dec;2(6):642-9. 36. Bickenbach KA, Veerapong J, Shao MY, et al. Resveratrol is an effective inducer of CArG-driven TNF-alpha gene therapy. Cancer Gene Ther. 2008 Mar;15(3):133-9. 37. Bader Y, Getoff N. Effect of resveratrol and mixtures of resveratrol and mitomycin C on cancer cells under irradiation. Anticancer Res. 2006 Nov-Dec;26(6B):4403-8. 38. Reagan-Shaw S, Mukhtar H, Ahmad N. Resveratrol imparts photoprotection of normal cells and enhances the efficacy of radiation therapy in cancer cells. Photochem Photobiol. 2008 Mar-Apr;84(2):415-21. 39. Carsten RE, Bachand AM, Bailey SM, Ullrich RL. Resveratrol reduces radiation-induced chromosome aberration frequencies in mouse bone marrow cells. Radiat Res. 2008 Jun;169(6):633-8. 40. Velioglu-Ogunc A, Sehirli O, Toklu HZ, et al. Resveratrol protects against irradiation-induced hepatic and ileal damage via its anti-oxidative activity. Free Radic Res. 2009;43(11):1060-71. 41. Chawla R, Arora R, Sagar RK, et al. 3-O-beta-D-Galactopyranoside of quercetin as an active principle from high altitude Podophyllum hexandrum and evaluation of its radioprotective properties. Z Naturforsch C. 2005 Sep-Oct;60(9-10):728-38. 42. Shukla SK, Chaudhary P, Kumar IP, et al. Protection from radiation-induced mitochondrial and genomic DNA damage by an extract of Hippophae rhamnoides. Environ Mol Mutagen. 2006 Dec;47(9):647-56. 43. Devipriya N, Sudheer AR, Srinivasan M, Menon VP. Quercetin ameliorates gamma radiation-induced DNA damage and biochemical changes in human peripheral blood lymphocytes. Mutat Res. 2008 Jun 30;654(1):1-7. 44. Uchida S, Ozaki M, Suzuki K, Shikita M. Radioprotective effects of (-)-epigallocatechin 3-O-gallate (green-tea tannin) in mice. Life Sci. 1992;50(2):147-52. 45. Kim SH, Kim SR, Lee HJ, et al. Apoptosis in growing hair follicles following gamma-irradiation and application for the evaluation of radioprotective agents. In Vivo. 2003 Mar-Apr;17(2):211-4. 46. Lee HJ, Kim JS, Moon C, et al. Modification of gamma-radiation response in mice by green tea polyphenols. Phytother Res. 2008 Oct;22(10):1380-3. 47. Avaialable at: http://www.iaea.org/cgi-bin/db.page.pl/pris.oprconst.htm. Accessed March 18, 2011. 48. Available at: http://www.iaea.org/newscenter/pressreleases/2007/prn200719.html. Accessed March 29, 2011. 49. Available at: http://www.world-nuclear.org/info/inf41.html. Accessed March 18, 2011. 50. Available at: http://www.nei.org/resourcesandstats/nuclear_statistics/usnuclearpowerplants/. Accessed March 18, 2011. 51. Landauer MR, Srinivasan V, Seed TM. Genistein treatment protects mice from ionizing radiation injury. J Appl Toxicol. 2003 Nov-Dec;23(6):379-85. 52. Zavodnik LB. Isoflavone genistein-8-c-glycoside prevents the oxidative damages in structure and function of rat liver microsomal membranes. Radiats Biol Radioecol. 2003 Jul-Aug;43(4):432-8. 53. Zhou Y, Mi MT. Genistein stimulates hematopoiesis and increases survival in irradiated mice. J Radiat Res (Tokyo). 2005 Dec;46(4):425-33. 54. Davis TA, Clarke TK, Mog SR, Landauer MR. Subcutaneous administration of genistein prior to lethal irradiation supports multilineage, hematopoietic progenitor cell recovery and survival. Int J Radiat Biol. 2007 Mar;83(3):141-51. 55. Singh VK, Grace MB, Parekh VI, Whitnall MH, Landauer MR. Effects of genistein administration on cytokine induction in whole-body gamma irradiated mice. Int Immunopharmacol. 2009 Nov;9(12):1401-10. 56. Dittmann K, Loffler H, Bamberg M, Rodemann HP. Bowman-Birk proteinase inhibitor (BBI) modulates radiosensitivity and radiation-induced differentiation of human fibroblasts in culture. Radiother Oncol. 1995 Feb;34(2):137-43. 57. Dittmann KH, Gueven N, Mayer C, Rodemann HP. The radioprotective effect of BBI is associated with the activation of DNA repair-relevant genes. Int J Radiat Biol. 1998 Aug;74(2):225-30. 58. Dittmann K, Mayer C, Kehlbach R, Rodemann HP. The radioprotector Bowman-Birk proteinase inhibitor stimulates DNA repair via epidermal growth factor receptor phosphorylation and nuclear transport. Radiother Oncol. 2008 Mar;86(3):375-82. 59. Gueven N, Dittmann K, Mayer C, Rodemann HP. Bowman-Birk protease inhibitor reduces the radiation-induced activation of the EGF receptor and induces tyrosine phosphatase activity. Int J Radiat Biol. 1998 Feb;73(2):157-62. 60. Dittmann KH, Dikomey E, Mayer C, Rodemann HP. The Bowman-Birk protease inhibitor enhances clonogenic cell survival of ionizing radiation-treated nucleotide excision repair-competent cells but not of xeroderma pigmentosum cells. Int J Radiat Biol. 2000 Feb;76(2):223-9. 61. Dittmann KH, Mayer C, Rodemann HP. Radioprotection of normal tissue to improve radiotherapy: the effect of the Bowman Birk protease inhibitor. Curr Med Chem Anticancer Agents. 2003 Sep;3(5):360-3. 62. Friedman M, Brandon DL. Nutritional and health benefits of soy proteins. J Agric Food Chem. 2001 Mar;49(3):1069-86. 63. Losso JN. The biochemical and functional food properties of the bowman-birk inhibitor. Crit Rev Food Sci Nutr. 2008 Jan;48(1):94-118. 64. Choudhary D, Chandra D, Kale RK. Modulation of radioresponse of glyoxalase system by curcumin. J Ethnopharmacol. 1999 Jan;64(1):1-7. 65. Inano H, Onoda M. Radioprotective action of curcumin extracted from Curcuma longa LINN: inhibitory effect on formation of urinary 8-hydroxy-2’-deoxyguanosine, tumorigenesis, but not mortality, induced by gamma-ray irradiation. Int J Radiat Oncol Biol Phys. 2002 Jul 1;53(3):735-43. 66. Srinivasan M, Rajendra Prasad N, Menon VP. Protective effect of curcumin on gamma-radiation induced DNA damage and lipid peroxidation in cultured human lymphocytes. Mutat Res. 2006 Dec 10;611(1-2):96-103. 67. Jagetia GC. Radioprotection and radiosensitization by curcumin. Adv Exp Med Biol. 2007;595:301-20. 68. Lee JC, Kinniry PA, Arguiri E, et al. Dietary curcumin increases antioxidant defenses in lung, ameliorates radiation-induced pulmonary fibrosis, and improves survival in mice. Radiat Res. 2010 May;173(5):590-601. 69. Herman-Antosiewicz A, Powolny AA, Singh SV. Molecular targets of cancer chemoprevention by garlic-derived organosulfides. Acta Pharmacol Sin. 2007 Sep;28(9):1355-64. 70. Singh SP, Abraham SK, Kesavan PC. In vivo radioprotection with garlic extract. Mutat Res. 1995 Dec;345(3-4):147-53. 71. Singh SP, Abraham SK, Kesavan PC. Radioprotection of mice following garlic pretreatment. Br J Cancer Suppl. 1996 Jul;27:S102-4. 72. Lee EK, Chung SW, Kim JY, et al. Allylmethylsulfide Down-Regulates X-Ray Irradiation-Induced Nuclear Factor-kappaB Signaling in C57/BL6 Mouse Kidney. J Med Food. 2009 Jun;12(3):542-51. 73. Jagetia GC, Baliga MS, Venkatesh P, Ulloor JN. Influence of ginger rhizome (Zingiber officinale Rosc) on survival, glutathione and lipid peroxidation in mice after whole-body exposure to gamma radiation. Radiat Res. 2003 Nov;160(5):584-92. 74. Jagetia G, Baliga M, Venkatesh P. Ginger (Zingiber officinale Rosc.), a dietary supplement, protects mice against radiation-induced lethality: mechanism of action. Cancer Biother Radiopharm. 2004 Aug;19(4):422-35. 75. Sharma A, Haksar A, Chawla R, et al. Zingiber officinale Rosc. modulates gamma radiation-induced conditioned taste aversion. Pharmacol Biochem Behav. 2005 Aug;81(4):864-70. 76. Haksar A, Sharma A, Chawla R, et al. Zingiber officinale exhibits behavioral radioprotection against radiation-induced CTA in a gender-specific manner. Pharmacol Biochem Behav. 2006 Jun;84(2):179-88. 77. Emerit I, Arutyunyan R, Oganesian N, et al. Radiation-induced clastogenic factors: anticlastogenic effect of Ginkgo biloba extract. Free Radic Biol Med. 1995 Jun;18(6):985-91. 78. Alaoui-Youssefi A, Lamproglou I, Drieu K, Emerit I. Anticlastogenic effects of Ginkgo biloba extract (EGb 761) and some of its constituents in irradiated rats. Mutat Res. 1999 Sep 15;445(1):99-104. 79. Emerit I, Oganesian N, Sarkisian T, et al. Clastogenic factors in the plasma of Chernobyl accident recovery workers: anticlastogenic effect of Ginkgo biloba extract. Radiat Res. 1995 Nov;144(2):198-205. 80. Sener G, Kabasakal L, Atasoy BM, et al. Ginkgo biloba extract protects against ionizing radiation-induced oxidative organ damage in rats. Pharmacol Res. 2006 Mar;53(3):241-52. 81. Dardano A, Ballardin M, Ferdeghini M, et al. Anticlastogenic effect of Ginkgo biloba extract in Graves’ disease patients receiving radioiodine therapy. J Clin Endocrinol Metab. 2007 Nov;92(11):4286-9. 82. Kumar M, Sharma MK, Saxena PS, Kumar A. Radioprotective effect of Panax ginseng on the phosphatases and lipid peroxidation level in testes of Swiss albino mice. Biol Pharm Bull. 2003 Mar;26(3):308-12. 83. Takeda A, Katoh N, Yonezawa M. Restoration of radiation injury by ginseng. III. Radioprotective effect of thermostable fraction of ginseng extract on mice, rats and guinea pigs. J Radiat Res (Tokyo). 1982 Jun;23(2):150-67. 84. Kim SH, Cho CK, Yoo SY, Koh KH, Yun HG, Kim TH. In vivo radioprotective activity of Panax ginseng and diethyldithiocarbamate. In Vivo. 1993 Sep-Oct;7(5):467-70. 85. Kim TH, Lee YS, Cho CK, Park S, Choi SY, Yool SY. Protective effect of ginseng on radiation-induced DNA double strand breaks and repair in murine lymphocytes. Cancer Biother Radiopharm. 1996 Aug;11(4):267-72. 86. Lee TK, Allison RR, O’Brien KF, et al. Ginseng reduces the micronuclei yield in lymphocytes after irradiation. Mutat Res. 2004 Jan 10;557(1):75-84. 87. Kim SH, Jeong KS, Ryu SY, Kim TH. Panax ginseng prevents apoptosis in hair follicles and accelerates recovery of hair medullary cells in irradiated mice. In Vivo. 1998 Mar-Apr;12(2):219-22. 88. Kim SH, Son CH, Nah SY, Jo SK, Jang JS, Shin DH. Modification of radiation response in mice by Panax ginseng and diethyldithiocarbamate. In Vivo. 2001 Sep-Oct;15(5):407-11. 89. Song JY, Han SK, Bae KG, et al. Radioprotective effects of ginsan, an immunomodulator. Radiat Res. 2003 Jun;159(6):768-74. 90. Lee TK, Johnke RM, Allison RR, O’Brien KF, Dobbs LJ, Jr. Radioprotective potential of ginseng. Mutagenesis. 2005 Jul;20(4):237-43. 91. Lee TK, O’Brien KF, Wang W, et al. Radioprotective effect of american ginseng on human lymphocytes at 90 minutes postirradiation: a study of 40 cases. J Altern Complement Med. 2010 May;16(5):561-7. 92. Kozurkova M, Hakova H, Misurova E. The effect of silymarin, a hepatoprotective substance, on liver histones in irradiated rats. Vet Med (Praha). 1994;39(2-3):85-92. 93. Kropacova K, Misurova E, Hakova H. Protective and therapeutic effect of silymarin on the development of latent liver damage. Radiats Biol Radioecol. 1998 May-Jun;38(3):411-5. 94. Tiwari P, Kumar A, Ali M, Mishra KP. Radioprotection of plasmid and cellular DNA and Swiss mice by silibinin. Mutat Res. 2010 Jan;695(1-2):55-60. 95. Ramadan LA, Roushdy HM, Abu Senna GM, Amin NE, El-Deshw OA. Radioprotective effect of silymarin against radiation induced hepatotoxicity. Pharmacol Res. 2002 Jun;45(6):447-54. 96. Selig C, Nothdurft W, Fliedner TM. Radioprotective effect of N-acetylcysteine on granulocyte/macrophage colony-forming cells of human bone marrow. J Cancer Res Clin Oncol. 1993;119(6):346-9. 97. Liu Y, Zhang H, Zhang L, et al. Antioxidant N-acetylcysteine attenuates the acute liver injury caused by X-ray in mice. Eur J Pharmacol. 2007 Dec 1;575(1-3):142-8. 98. Kilciksiz S, Demirel C, Erdal N, et al. The effect of N-acetylcysteine on biomarkers for radiation-induced oxidative damage in a rat model. Acta Med Okayama. 2008 Dec;62(6):403-9. 99. Baier JE, Neumann HA, Moeller T, Kissler M, Borchardt D, Ricken D. Radiation protection through cytokine release by N-acetylcysteine. Strahlenther Onkol. 1996 Feb;172(2):91-8. 100. Demirel C, Kilciksiz S, Ay OI, Gurgul S, Ay ME, Erdal N. Effect of N-acetylcysteine on radiation-induced genotoxicity and cytotoxicity in rat bone marrow. J Radiat Res (Tokyo). 2009 Jan;50(1):43-50. 101. Tiwari P, Kumar A, Balakrishnan S, Kushwaha HS, Mishra KP. Radiation-induced micronucleus formation and DNA damage in human lymphocytes and their prevention by antioxidant thiols. Mutat Res. 2009 May 31;676(1-2):62-8. 102. Wambi C, Sanzari J, Wan XS, et al. Dietary antioxidants protect hematopoietic cells and improve animal survival after total-body irradiation. Radiat Res. 2008 Apr;169(4):384-96. 103. Fontecave M, Atta M, Mulliez E. S-adenosylmethionine: nothing goes to waste. Trends Biochem Sci. 2004 May;29(5):243-9. 104. Lu SC. S-Adenosylmethionine. Int J Biochem Cell Biol. 2000 Apr;32(4):391-5. 105. Batra V, Mishra KP. Modulation of DNA methyltransferase profile by methyl donor starvation followed by gamma irradiation. Mol Cell Biochem. 2007 Jan;294(1-2):181-7. 106. Batra V, Sridhar S, Devasagayam TP. Enhanced one-carbon flux towards DNA methylation: Effect of dietary methyl supplements against gamma-radiation-induced epigenetic modifications. Chem Biol Interact. 2010 Feb 12;183(3):425-33. 107. Yong LC, Petersen MR, Sigurdson AJ, Sampson LA, Ward EM. High dietary antioxidant intakes are associated with decreased chromosome translocation frequency in airline pilots. Am J Clin Nutr. 2009 Nov;90(5):1402-10. 108. Chen B, Zhou XC. Protective effect of natural dietary antioxidants on space radiation-induced damages. Space Med Med Eng (Beijing). 2003;16 Suppl:514-8. 109. Ben-Amotz A, Yatziv S, Sela M, et al. Effect of natural beta-carotene supplementation in children exposed to radiation from the Chernobyl accident. Radiat Environ Biophys. 1998 Oct;37(3):187-93. 110. Burns FJ, Chen S, Xu G, Wu F, Tang MS. The action of a dietary retinoid on gene expression and cancer induction in electron-irradiated rat skin. J Radiat Res (Tokyo). 2002 Dec;43 Suppl:S229-32. 111. Nubel T, Dippold W, Kaina B, Fritz G. Ionizing radiation-induced E-selectin gene expression and tumor cell adhesion is inhibited by lovastatin and all-trans retinoic acid. Carcinogenesis. 2004 Aug;25(8):1335-44. 112. Zhang R, Burns FJ, Chen H, Chen S, Wu F. Alterations in gene expression in rat skin exposed to 56Fe ions and dietary vitamin A acetate. Radiat Res. 2006 May;165(5):570-81. 113. Marekova M, Vavrova J, Vokurkova D, Psutka J. Modulation of ionizing radiation-induced apoptosis and cell cycle arrest by all-trans retinoic acid in promyelocytic leukemia cells (HL-60). Physiol Res. 2003;52(5):599-606. 114. Vorotnikova E, Tries M, Braunhut S. Retinoids and TIMP1 prevent radiation-induced apoptosis of capillary endothelial cells. Radiat Res. 2004 Feb;161(2):174-84. 115. Lenton KJ, Therriault H, Fulop T, Payette H, Wagner JR. Glutathione and ascorbate are negatively correlated with oxidative DNA damage in human lymphocytes. Carcinogenesis. 1999 Apr;20(4):607-13. 116. Konopacka M, Rzeszowska-Wolny J. Antioxidant vitamins C, E and beta-carotene reduce DNA damage before as well as after gamma-ray irradiation of human lymphocytes in vitro. Mutat Res. 2001 Apr 5;491(1-2):1-7. 117. Konopacka M, Palyvoda O, Rzeszowska-Wolny J. Inhibitory effect of ascorbic acid post-treatment on radiation-induced chromosomal damage in human lymphocytes in vitro. Teratog Carcinog Mutagen. 2002;22(6):443-50. 118. Witenberg B, Kletter Y, Kalir HH, et al. Ascorbic acid inhibits apoptosis induced by X irradiation in HL60 myeloid leukemia cells. Radiat Res. 1999 Nov;152(5):468-78. 119. Waldren CA, Vannais DB, Ueno AM. A role for long-lived radicals (LLR) in radiation-induced mutation and persistent chromosomal instability: counteraction by ascorbate and RibCys but not DMSO. Mutat Res. 2004 Jul 13;551(1-2):255-65. 120. Prasad KN, Kumar B, Yan XD, Hanson AJ, Cole WC. Alpha-tocopheryl succinate, the most effective form of vitamin E for adjuvant cancer treatment: a review. J Am Coll Nutr. 2003 Apr;22(2):108-17. 121. Singh VK, Shafran RL, Jackson WE, 3rd, Seed TM, Kumar KS. Induction of cytokines by radioprotective tocopherol analogs. Exp Mol Pathol. 2006 Aug;81(1):55-61. 122. Singh VK, Brown DS, Kao TC. Alpha-tocopherol succinate protects mice from gamma-radiation by induction of granulocyte-colony stimulating factor. Int J Radiat Biol. 2010 Jan;86(1):12-21. 123. Kayan M, Naziroglu M, Celik O, Yalman K, Koylu H. Vitamin C and E combination modulates oxidative stress induced by X-ray in blood of smoker and nonsmoker radiology technicians. Cell Biochem Funct. 2009 Oct;27(7):424-9. 124. Alpha-lipoic acid. Monograph. Altern Med Rev. 2006 Sep;11(3):232-7. 125. Smith JR, Thiagaraj HV, Seaver B, Parker KK. Differential activity of lipoic acid enantiomers in cell culture. J Herb Pharmacother. 2005;5(3):43-54. 126. Streeper RS, Henriksen EJ, Jacob S, Hokama JY, Fogt DL, Tritschler HJ. Differential effects of lipoic acid stereoisomers on glucose metabolism in insulin-resistant skeletal muscle. Am J Physiol. 1997 Jul;273(1 Pt 1):E185-91. 127. Brown SL, Kolozsvary A, Liu J, Jenrow KA, Ryu S, Kim JH. Antioxidant diet supplementation starting 24 hours after exposure reduces radiation lethality. Radiat Res. 2010 Apr;173(4):462-8. 128. Zueva NA, Metelitsa LA, Kovalenko AN, Efimov AS. Immunomodulating effect of berlithione in clean-up workers of the Chernobyl nuclear plant accident. Lik Sprava. 2002;(1):24-6. 129. Davis GD, Masilamoni JG, Arul V, et al. Radioprotective effect of DL-alpha-lipoic acid on mice skin fibroblasts. Cell Biol Toxicol. 2009 Aug;25(4):331-40. 130. Dani V, Dhawan DK. Radioprotective role of zinc following single dose radioiodine (131I) exposure to red blood cells of rats. Indian J Med Res. 2005 Oct;122(4):338-42. 131. Dani V, Dhawan D. Zinc as an antiperoxidative agent following iodine-131 induced changes on the antioxidant system and on the morphology of red blood cells in rats. Hell J Nucl Med. 2006 Jan-Apr;9(1):22-6. 132. Floersheim GL, Chiodetti N, Bieri A. Differential radioprotection of bone marrow and tumour cells by zinc aspartate. Br J Radiol. 1988 Jun;61(726):501-8. 133. Epperly MW, Gretton JE, Sikora CA, et al. Mitochondrial localization of superoxide dismutase is required for decreasing radiation-induced cellular damage. Radiat Res. 2003 Nov;160(5):568-78. 134. Alcaraz M, Acevedo C, Castillo J, et al. Liposoluble antioxidants provide an effective radioprotective barrier. Br J Radiol. 2009 Jul;82(979):605-9. 135. Qishen P, Guo BJ, Kolman A. Radioprotective effect of extract from Spirulina platensis in mouse bone marrow cells studied by using the micronucleus test. Toxicol Lett. 1989 Aug;48(2):165-9. 136. Badr FM, El Habit OH, Harraz MM. Radioprotective effect of melatonin assessed by measuring chromosomal damage in mitotic and meiotic cells. Mutat Res. 1999 Aug 18;444(2):367-72. 137. Koc M, Buyukokuroglu ME, Taysi S. The effect of melatonin on peripheral blood cells during total body irradiation in rats. Biol Pharm Bull. 2002 May;25(5):656-7. 138. Shetty TK, Satav JG, Nair CK. Protection of DNA and microsomal membranes in vitro by Glycyrrhiza glabra L. against gamma irradiation. Phytother Res. 2002 Sep;16(6):576-8. 139. Singh I, Sharma A, Nunia V, Goyal PK. Radioprotection of Swiss albino mice by Emblica officinalis. Phytother Res. 2005 May;19(5):444-6. 140. Jindal A, Soyal D, Sharma A, Goyal PK. Protective effect of an extract of Emblica officinalis against radiation-induced damage in mice. Integr Cancer Ther. 2009 Mar;8(1):98-105. 141. Del Bano MJ, Castillo J, Benavente-Garcia O, et al. Radioprotective-antimutagenic effects of rosemary phenolics against chromosomal damage induced in human lymphocytes by gamma-rays. J Agric Food Chem. 2006 Mar 22;54(6):2064-8. 142. Papadopoulou F, Efthimiou E. Thyroid cancer after external or internal ionizing irradiation. Hell J Nucl Med. 2009 Sep-Dec;12(3):266-70. 143. O’Donnell MR, Abboud CN, Altman J, et al. Acute myeloid leukemia. J Natl Compr Canc Netw. 2011 Mar;9(3):280-317. 144. Sovacool BK. The costs of failure: A preliminary assessment of major energy accidents, 1907-2007. Energy Policy. 2008 May;36(5):1802-20. 145. Sovacool BK. The accidental century - prominent energy accidents in the last 100 years. Exploration and Production: Oil and Gas Review. 2009;7(2):132-7. 146. Sovacool BK. A critical evaluation of nuclear power and renewable electricity in Asia. Journal of Contemporary Asia. 2010 Aug;40(3):386. 147. Hallenbeck WH. Radiation Protection. Boca Raton, FL: CRC Press; 1994. 148. Mould RF. Chernobyl Record: The Definitive History of the Chernobyl Catastrophe. Boca Raton, FL: CRC Press; 2000. 149. Tronko1 M, Bogdanova T, Voskoboynyk L, Zurnadzhy L, Shpak V, Gulak L. Radiation induced thyroid cancer: fundamental and applied aspects. Exp Oncol. 2010 Sep;32(3):200-4. |
Vindication For Linus Pauling |
 |
A new government study says that radioactive fallout from nuclear weapons testing has caused at least 15,000 cancer deaths in the United States. This report was prepared as a joint effort by the National Cancer Institute and Centers for Disease Control and Prevention. Here is a chilling revelation from this report:
“Any person living in the contiguous United States since 1951 has been exposed to radioactive fallout, and all organs and tissues of the body have received some radiation exposure.”
For those who don’t know, more than 2,000 nuclear tests have been conducted worldwide since the first nuclear bomb was built. The latest government report considered only above-ground tests that took place between 1951 and 1962. This study uncovered intense radioactive “hot spots” in the continental United States all the way from California and Washington to Vermont, New Hampshire, and North Carolina.1
This report of 15,000 cancer deaths, however, is but preliminary. The full study is still being withheld from the public. Critics are accusing the Federal government of slowing the release of this information to minimize the consequences.
For decades, the Federal government contended that radioactive fallout from nuclear testing was harmless. Government propaganda films in the 1950s even showed American children playing in fresh radioactive ash to demonstrate that it was as “safe as snow.”1
Now that the lethal consequences of the government’s deceit are being exposed, we commemorate the scientist who risked imprisonment for organizing protests that eventually caused the United States and [the former] Soviet Union to ban above-ground nuclear testing.
|
Linus Pauling: The Scientist
Linus Pauling is the only person to ever win two undivided Nobel Prizes. The New Scientist magazine ranked Dr. Pauling as one of the twenty greatest scientists to ever live, an honor shared with such figures as Albert Einstein, Charles Darwin, and Isaac Newton.
Dr. Pauling’s research focused primarily on physical chemistry. In 1939 he published The Nature of the Chemical Bond and the Structure of Molecules and Crystals and was awarded the Nobel Prize in Chemistry in 1954.
During World War II, Pauling participated in scientific enterprises deemed vital to the protection of the country. Early in the war he was a consultant to the National Defense Research Commission and later became a member of the Research Board for National Security. For his contributions, which included work on rocket propellants, on an oxygen deficiency indicator for pressurized space, such as that in submarines and aircraft, and on a substitute for human serum in medical treatment, he was awarded the Presidential Medal of Merit in 1948.
Pauling’s interest in the “behavior” of molecules led him from physical chemistry to biological chemistry. Dr. Pauling’s research into amino acids resulted in the development of the first substitute for blood plasma.
In 1950, Dr. Pauling constructed the first satisfactory model of a protein molecule, a discovery that has implications for the understanding of the living cell. He studied and published papers on subjects as diverse as the effects of blood cell abnormalities, the relationship between molecular abnormality and heredity, the possible chemical basis of mental retardation, the functioning of anesthetics, the relationship of vitamin C deficiency to heart disease, etc.
Many of today’s scientific and medical breakthroughs emanate from Linus Pauling’s pioneering research in the fields of both physical and biological chemistry.
How Linus Pauling Got into Trouble
Linus Pauling knew that radioactive fallout–generated free radicals would cause cancer and other diseases in humans. Pauling joined with Albert Einstein and five others to form the Emergency Committee of Atomic Scientists. Their mission was to inform the public about the dangerous consequences that nuclear weapons and nuclear testing held for civilization.
In 1957, Pauling wrote a scientific appeal petition calling for a nuclear test ban treaty and distributed it throughout the scientific community. He soon gathered over 9,000 signatures from 49 countries, including 2,000 American scientists. In 1958, Pauling presented the petition to the Secretary-General of the United Nations, announcing that it represented the general consensus of the world’s scientists and their plea for a ban on future nuclear testing.
Pauling gave hundreds of lectures against nuclear weapons testing and war. Unfortunately, he toured during a time of heightened Cold War suspicions and was marked a Communist supporter. The Federal government refused to give Pauling a passport, thus denying him the opportunity to attend international scientific conventions. Pauling was twice subpoenaed to appear before congressional committees investigating anti-American activities to declare that he was not a Communist. On October 11, 1960, Pauling was threatened to be held in contempt of Congress because he refused to reveal the names of those who helped circulate his petition to ban nuclear testing.
Despite unrelenting governmental oppression, Pauling remained undaunted and continued his crusade by writing a draft resolution for a nuclear test ban treaty. He sent letters and copies of his resolution to both President Kennedy and Premier Khrushchev. The two superpowers eventually agreed on a limited test ban treaty, one that was strikingly similar to Pauling’s. The treaty went into effect on October 10, 1963, the very day it was announced that Pauling was to receive his second Nobel Prize.
Too Far Ahead of His Time
By disseminating his knowledge about the lethal dangers of radioactive fallout, Pauling became a target of government persecution, harassment in the press, and charges of working for the enemy. He could have been jailed for refusing to provide Congress with the names of those involved in gathering more than 9,000 signatures for the scientific petition to ban above-ground nuclear testing.
We are now learning that the government knew about the effects of above-ground nuclear testing, but covered it up. In the 1950s for example, government officials notified suppliers of photographic film of expected fallout patterns so they could protect their film, but did not share the information with milk producers. Many children drank this radioactive contaminated milk.
A 1997 report by the National Cancer Institute indicated that farm children who drank goats’ milk in the 1950s in high fallout areas were as severely exposed as the worst exposed children after the 1986 Chernobyl nuclear plant accident. Death rates from leukemia and other cancers, and diseases caused by the Chernobyl accident, are estimated to kill tens of thousands in the future.2
 |
Environmental groups are calling for the US government to expand its compensation program for test site “downwinders” to include hot spots thousands of miles from the test sites, and to formulate and implement a comprehensive response to the public health threat posed by the fallout.
This preliminary report about the lethal effects of nuclear testing has alarmed some members of Congress, including Sen. Tom Harkin of Iowa. “What we know is maybe the tip of the iceberg here,” Harkin said. “We know that there’s been upwards of perhaps 15,000 deaths that are attributable to these nuclear tests.” Congress received the preliminary report last August. The report was endorsed by the prestigious Institute for Energy and Environmental Research, but the government has yet to formulate a public health response.
“People have a right to know if they were exposed, where the big areas of fallout were, and they need to be screened and told what to do to protect their health,” Senator Harkin said.
It is interesting to note that what Senator Harkin advocates today would have been considered heresy in the 1950s, since the government’s official position at that time was that radioactive fallout was harmless.
Forty-five years ago, Dr. Linus Pauling formulated a public health response to eradicate this problem, but the Federal government chose instead to persecute this brilliant scientist and humanist so that the practice of raining radioactive fallout throughout the United States could continue.
As is too often the case, when the government makes a criminal accusation against a political dissident (in this case Linus Pauling), history later shows that it was the government itself that was involved in the sinister activities. What could be more anti-American than inflicting cancer on 15,000 innocent people?
Comment from The New York Times, February 28, 2002 | |
Dr. Linus Pauling’s warnings of the increased incidence of cancer due to the fallout from atmospheric atomic weapons testing & the emissions of fission reactors were largely ignored by the mainstream media during his lifetime. Finally, in 1997, 40 years after his petition to the United Nations was denounced as “pro-communist,” the US National Cancer Institute announced that large numbers of people, especially children, were exposed to dangerous levels of radiation from fallout. The damage done by the US, British, & USSR testing until 1963, of testing by France & China and, more recently, by Pakistan, India, et al, dispersed vast amounts of long-lived radioactive materials into the atmosphere. Since much of this consists of elements such as iodine, cesium, strontium, etc., which falling into the oceans, are ingested by oceanic organisms such as algae, plankton, etc. &, falling onto the ground, are taken up by grazing animals such as sheep & cattle, it becomes increasingly concentrated the higher it goes up the food chain. While we have until now managed to avoid the catastrophe of nuclear war, it appears that those responsible for protecting the security of our respective nations have, in fact, poisoned life on Earth for years to come. |
Linus Pauling’s Theory about Vitamin C and Heart Attack
Linus Pauling never stopped taking controversial positions. In the 1960s, he began to investigate the role that vitamin C played in human health. Pauling postulated that a cause of atherosclerosis is a lifelong vitamin C deficiency.
One of the great misfortunes of human evolution, Pauling explained, was when our human ancestors lost their ability to manufacture vitamin C. Ever since proto-humans moved out of fruit- and vegetable-rich habitats, Pauling said, they have suffered great deficiencies of vitamin C. Pauling recommended that people make up for this deficiency with daily doses of vitamin C much greater than the 60 mg recommended by the government.
Pauling laid out a molecular basis to explain vitamin C’s connection with lipoprotein-a, a substance whose levels in the blood have been linked to cardiovascular disease. Lipoprotein-a is also a major component of the plaques found in the blood vessels of atherosclerosis patients.
Pauling has published studies asserting that lipoprotein-a is a surrogate for vitamin C, serving to strengthen blood vessel walls in the absence of adequate amounts of the vitamin in the diet. Pauling noted that animals that manufacture their vitamin C have very little lipoprotein-a in their blood.
Pauling was convinced that high doses of vitamin C could help prevent the onset of cardiovascular disease, inhibiting the formation of disease-promoting lesions on blood vessel walls and perhaps decreasing the production of lipoprotein-a in the blood.
Linus Pauling’s position on vitamin C once again put him under intense criticism, this time from the medical establishment who asserted that vitamin C had nothing to do with heart attack risk.
 |
| The only reason Linus Pauling was not thrown in jail for promoting the benefits of vitamin C is that he did not sell it. Before 1994, the FDA prohibited distributors of vitamin supplements from making health claims. |
Linus Pauling Again Exonerated
Over the past 12 years, a large volume of published studies has supported Linus Pauling’s position on the role of vitamin C and heart disease. Many of these studies look at the beneficial effects that vitamin C has on the arterial wall, but what is most impressive are human epidemiological studies showing that people with high levels of vitamin C live longer and suffer fewer heart attacks compared to those with low vitamin C.
One of the first human studies that substantiated the benefits of vitamin supplements was announced in 1992 and showed that men who took 800 mg a day of vitamin C lived six years longer than those who consumed the FDA’s recommended daily allowance of 60 mg a day. This ten-year study, published in the journal Epidemiology,3 showed that high vitamin C intake extended average life span and reduced mortality from cardiovascular disease.
A compelling report that high-potency supplements extend life span in humans was published in the August 1996 issue of the American Journal of Clinical Nutrition. This study involved 11,178 elderly people, who participated in a trial to establish the effects of vitamin supplements on mortality. When the effects of vitamin C and E were compared, overall mortality was reduced by 42%. What made these findings significant was that the study compared people who took low potency “one-a-day” multiple vitamins to those who took higher potency vitamin C and E supplements. Only the participants taking high-dose vitamin C and E supplements benefitted.4
A study published in the British Medical Journal evaluated 1,605 randomly selected men in Finland aged 42 to 60 years between 1984 and 1989. None of these men had evidence of pre-existing heart disease. After adjusting for other confounding factors, men who were deficient in vitamin C had 3.5 times more heart attacks than men who were not deficient in vitamin C. The scientists’ conclusion was, “Vitamin C deficiency, as assessed by low plasma ascorbate concentration, is a risk factor for coronary heart disease.”5
In a study published last year in The Lancet, researchers at Cambridge University in England looked at serum vitamin C and how long people lived. People who had the lowest levels of vitamin C were twice as likely to die compared to those with the highest serum vitamin C levels. This study was based on the findings from over 19,000 people.6
Does Vitamin C Cause Kidney Stones?
Linus Pauling came under attack by medical doctors who asserted that vitamin C caused kidney stones. Based on Dr. Pauling’s molecular knowledge of chemistry, he meticulously rebutted these unfounded allegations. What Dr. Pauling lacked in the 1960s and 1970s, however, were human studies to validate that vitamin C did not increase kidney stone risk.
Dr. Pauling was exonerated again by a report from Harvard Medical School that showed no increased risk of kidney stones when evaluating 85,557 women over a 14-year study period. This report, published in the April 1999 issue of the Journal of the American Society of Nephrology, showed that women who consumed 1,500 mg a day or more of vitamin C were no more likely to develop kidney stones than women who consumed less than 250 mg of vitamin C a day. The study did reveal that women who consumed 40 mg or more of vitamin B6 were 34% less likely to develop kidney stones compared to women taking fewer than 3 mg a day of B6.7
The only reason Linus Pauling was not thrown in jail for promoting the benefits of vitamin C is that he did not sell it. Before 1994, the FDA prohibited distributors of vitamin supplements from making health claims.
Can We Stop Persecuting Today’s Linus Paulings?
 |
| How to Live Longer and Feel Better |
Those with new ideas often face fierce attack by the establishment and the Federal government. A recent example was the announcement that human embryonic stem cells had been produced and that there is now an opportunity to cure many of today’s lethal diseases.
You would think that the scientist who made this remarkable discovery, Dr. Mike West, would be proclaimed a hero. Instead, government leaders immediately vowed to pass new laws to make it a crime to create embryonic stem cells for therapeutic cloning purposes. In Senate hearings, scientists and people afflicted with disease are appealing to lawmakers to not ban therapeutic cloning research.
Our concern is that only a miniscule number of brilliant minds like Linus Pauling are ever born. When Linus Pauling stated that radioactive fallout caused cancer in humans, he was ridiculed, persecuted and almost incarcerated. Now 45 years later, Pauling has been proven right. This vindication does nothing for the 15,000 Americans who have perished from radioactive fallout-induced cancer.
Today, there are pockets of exceptional intelligence that are stifled by bureaucratic red tape. In order to create the scientific renaissance needed to radically extend the healthy human life span, we must break down the barriers that suppress implementation of new ideas.
We as citizens and Life Extension® members must protect those brilliant minds (the Linus Paulings of today) who may be too intimidated to risk their personal freedom to bring forth the scientific truth.









